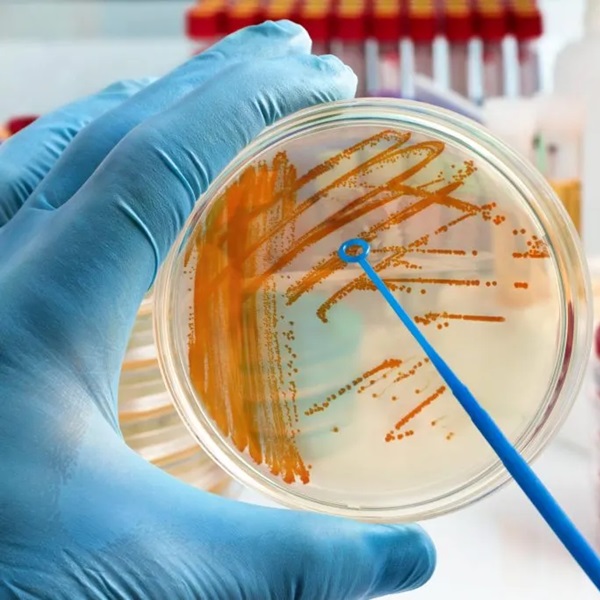

Australia's Leading Environmental Sample Testing Laboratory - SESALAB
SESALAB NATA Accredited Environmental Sample Testing Laboratory in Sydney

NATA Accredited Environmental Sample Testing Laboratory Australia
SESALAB is the environmental testing lab of SESA Safety & Environmental Services Australia. It meets ISO/IEC 17025 requirements and is NATA accredited for testing mould, asbestos, and synthetic mineral fibres in air, surface, bulk, and soil samples (Accreditation Number 20403).
SESALAB is pursuing additional NATA accreditations to supplement our dependable and quality-assured testing services. Our team of experts consists of highly qualified specialists in indoor air quality, chemistry, mycology, microbiology, and occupational hygiene.
SESALAB Clients include
- Occupational Hygienists
- Asbestos assessors and hazardous materials consultants
- Building biologists
- Building inspectors
- Licensed asbestos and hazardous materials remediation contractors
- Building, renovation and demolition firms
- Civil and environmental works contractors
- Certified mould remediators and building restoration firms
- Homeowners and commercial/industrial building managers
- Schools, hospitals/health care facilities, retirement villages, libraries, museums
- Insurance, loss adjusters, real estate and legal firms.

Microbiology and Chemical Sample Testing Offered by SESALAB

Asbestos Testing
SESALAB are trusted experts in asbestos testing, providing reliable assessments for homes, workplaces, and industrial sites. Our advanced laboratory in Sydney delivers accurate, easy-to-understand reports, helping you identify and manage asbestos risks.
We serve the greater Sydney area and clients across Australia, ensuring safe and compliant environments with expert analysis and professional service.
- Asbestos fibre identification analysis for bulk samples and soil (NATA accredited to AS4964)
- Gravimetric analysis of asbestos in soil to NEPM/WA Guidelines (Non-NATA)
- Asbestos fibre air monitoring and fibre counting (NATA accredited) in accordance with Guidance Note on the Membrane Filter Method for Estimating Airborne Asbestos Fibres 2nd Edition
- Synthetic mineral fibre (SMF) air monitoring and fibre counting (NATA accredited) in accordance with Guidance Note on the Membrane Filter Method for the Estimation of Airborne Synthetic Mineral Fibres
Mould Testing & Non-Fungal Particles Analysis by Direct Microscopy Examination (DME)
- Laboratory analysis of airborne mould samples (NATA accredited) collected on spore trap cassette or slit impactor (eg. Air-O-Cell, Allergenco-D, SKC VersaTrap, MouldSnap, Micro5 Posi-Track). The samples are analysed in accordance with the Method ASTM D7391 – 17e1 Standard Test Method for Categorization and Quantification of Airborne Fungal Structures in an Inertial Impaction Sample by Optical Microscopy
- Laboratory analysis of surface mould samples (NATA accredited) collected on tape (eg. cellophane tape, fungi tape, biotape), swabs or bulk materials such as plasterboard, wallpaper, pieces of carpets, insulation material, dust, wood and other matrices. The samples are analysed in accordance with ASTM Standard Designation: D7658 – 17 Standard Test Method for Direct Microscopy of Fungal Structures from Tape
- Laboratory analysis of combustion fire residues – Soot, Char, Ash and assemblage analysis by direct microscopy examination of air and surface samples. Soon to be NATA accredited
- Laboratory analysis of fungal and non-fungal particulates – comprehensive microscopy analysis suite of air and surface samples (Mould, Pollen, Combustion Particles (Soot, Char, Ash), Skin Cell Fragments, Fibres (Cellulosic/Synthetic), Fibreglass, Biogenic Particles, Corrosion & Friction Particles, Insects & Parts and Crystalline Mineral Particles). Soon to be NATA accredited.

Viable Mould & Bacteria Testing by Culture
SESALAB is a leading mould & bacteria testing laboratory based in Sydney. We’re recognised for delivering high-quality, easy-to-understand reports and solving complex air quality issues in homes, workplaces, and factories. Our services extend across Sydney and throughout Australia.
With a leading Australian mould & bacteria testing laboratory, we analyse and interpret data on some of the most severe and complex mould contaminations across the country.
- Laboratory analysis of viable mould, yeast and bacteria – air plates (impaction), settle plates, gelatine filters, surface swabs, bulk samples and liquid. Soon to be NATA accredited
E coli & Coliforms Testing
At SESALAB, we provide E coli & Coliforms Testing to assess surface contamination in various environments. Using advanced laboratory techniques, we analyse surface swabs and other media to detect Escherichia coli (E. coli) and coliform bacteria, which serve as key indicators of hygiene, water quality, and potential faecal contamination.
Our NATA accredited laboratory ensures accurate and reliable results, helping businesses and industries maintain health and safety compliance. Whether for food production, healthcare, commercial facilities, or environmental monitoring, our testing services support effective sanitation strategies and risk management.
- Laboratory analysis of E Coli & Coliforms – in surface swabs and other media as indicators of surface contamination.

Sample Submission & Testing Process
Sending Samples with Courier or Drop off: You can send the samples by Express Post, courier or drop of in person at reception or in the sample submission drop box located at the front door of our unit at: SESALAB
Unit 53/3 Kelso Crescent, Moorebank, NSW, 2170
If you were unable to complete the chain of custody form prior to samples submission, you can obtain the form from SESALAB reception at the time of samples drop off.
Arranging Pickup From Work Site: Alternatively, for certain samples we can arrange pickup of your samples by courier with prior arrangement. A fee for the service would apply.
SESALAB accepts no responsibility or liability of costs on any samples damaged or lost in transit.
Samples Labeling & Packaging: Please ensure all samples submitted to SESALAB are correctly labelled with identifier and are safely packaged. The chain of custody form should accompany the samples batch. Alternatively, if not possible to complete the chain of custody form in time, the completed form can be emailed to lab@sesa.com.au. Note that the lab is unable to process samples without a completed chain of custody form.
